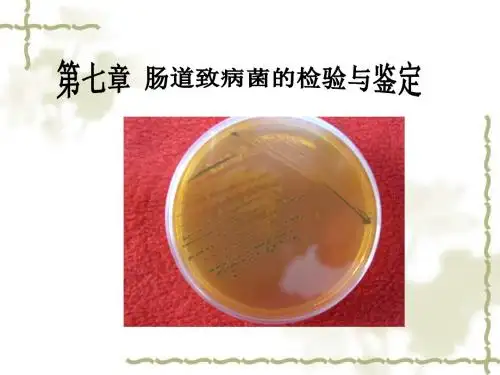

肠道致病菌的检验和鉴定培训课件
- 格式:ppt
- 大小:2.62 MB
- 文档页数:9

肠道致病菌的分离与鉴定一、实验目的(1)掌握肠道致病菌的分离、鉴定的主要步骤(2)掌握平板划线分离法(3)掌握玻片凝集试验的操作方法以及实际意义二、实验材料(1)实验仪器:试管、玻片、酒精灯、接种针、接种环、试管架、(2)实验试剂:生理盐水、细菌培养基、伤寒诊断血清、伊红美蓝培养基(EMB、克氏双糖铁培养基(KIA)、葡萄糖发酵管、乳糖发酵管、甘露醇发酵管、尿素培养基、蛋白胨水、半固体培养基三、实验流程(1)肠道致病菌的分离①待测标本的制作:把接种环放置于点燃的酒精灯火焰处对其进行灭菌,用已灭菌的接种环在细菌培养基中取少量待测细菌于盛有5ml生理盐水的试管中,混匀。
②细菌的分离接种:用接种环取适量配置好的细菌悬液,在酒精灯附近进行划线分离法接种细菌于EMBt养基。
将培养基置于37C培养18~24小时。
(2)肠道致病菌的纯化①单菌落接种:从已培养待测细菌的EMB培养基上用已灭菌的接种针挑取某单个菌落接种到KIA培养基上,一部分直接深入培养基中底部,一部分直接涂抹于斜面处,置于37 C培养18~24小时。
②待测细菌的初步判断:取出已纯化培养待测细菌的KIA培养基,观察现象,初步断定该细菌是致病菌或是非致病菌。
(3)肠道致病菌的鉴定①生化鉴定:分别取葡萄糖、乳糖、甘露醇发酵管各一只(注意管内的小倒管则应充满液体,不含气泡),用已灭菌的接种针取已培养的KIA 培养基上的培养物接种于各发酵管,将各发酵管于37 C培养18~24小时。
取出并观察记录现象。
(注意每次使用接种针前都应用酒精灯火焰进行灭菌)②动力检查:用已灭菌的接种针取KIA培养基上的培养物分别接种于蛋白胨水、尿素培养基、半固体培养基中,将各个培养基于37 C 培养18~24小时。
取出后将靛基质(吲哚)加入到蛋白胨水培养基中,并观察记录现象。
(注意每次使用接种针前都应用酒精灯火焰进行灭菌)③血清学鉴定:取洁净玻片一张,将其用蜡笔分为两格,两边各取生理盐水一滴,再用已灭菌的接种环分别取KIA培养基上的培养物加入两格中,与生理盐水混匀不摊开。